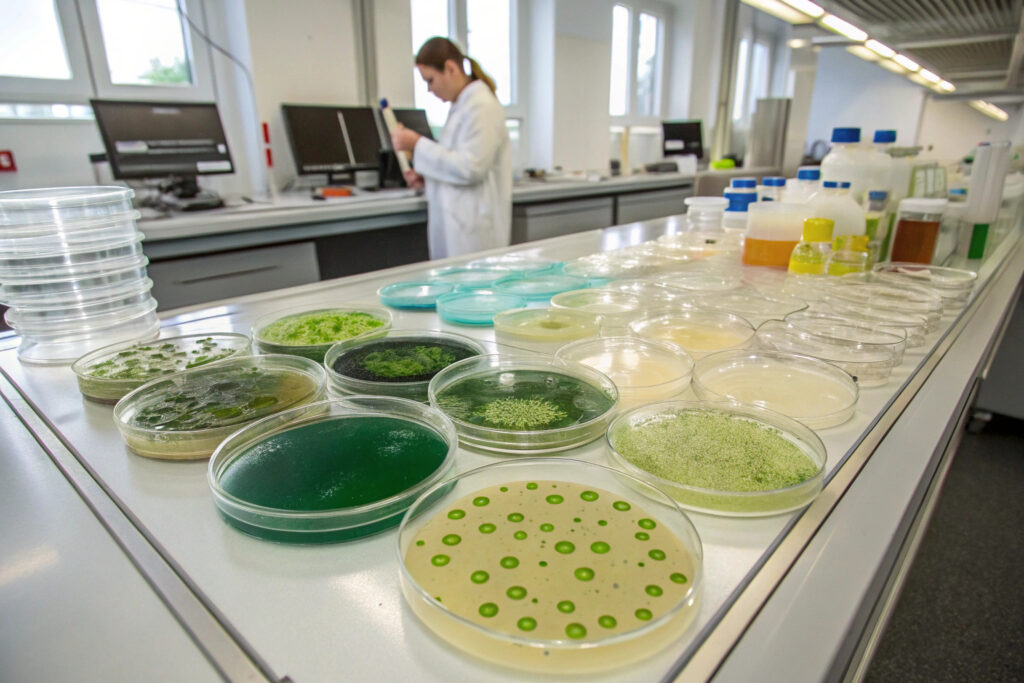

The intersection of biotechnology and air purification has given rise to revolutionary biohybrid systems that harness living organisms' natural capabilities to create self-sustaining air purification. For mask manufacturers and environmental technology developers, these photosynthetic air purification systems represent a paradigm shift—moving from passive filtration to active, biological air regeneration that produces oxygen while removing carbon dioxide and volatile organic compounds.
Biohybrid photosynthetic air purification systems integrate living photosynthetic microorganisms (typically algae or cyanobacteria) with advanced material science and photonic engineering to create self-regenerating air purification platforms that convert exhaled CO₂ into oxygen through natural photosynthesis while simultaneously capturing airborne pollutants. These systems represent a fundamental advancement over conventional filtration, offering continuous air quality improvement without filter replacement and actually generating net positive oxygen output. The latest developments focus on enhancing efficiency, longevity, and practical integration into wearable and enclosed environments.
The global biohybrid technology market is projected to reach $2.3 billion by 2028, with air purification applications experiencing particularly rapid growth. Research in Nature Biotechnology demonstrates that optimized photosynthetic systems can achieve CO₂-to-O₂ conversion efficiencies exceeding 85% under controlled illumination while maintaining viable microbial cultures for months without replacement. Let's explore the most significant recent advancements in biohybrid photosynthetic air purification systems relevant to respiratory protection.
What Microorganism Strains Offer Optimal Performance?
The selection of photosynthetic microorganisms determines the fundamental purification capabilities, environmental tolerance, and maintenance requirements of biohybrid systems. Different strains offer distinct advantages for specific applications.
How Do Chlorella Species Compare to Cyanobacteria?
Chlorella vulgaris and related microalgae offer exceptionally high photosynthetic efficiency (up to 8-10% light-to-chemical energy conversion) and robust growth in diverse conditions, making them ideal for consumer applications. Cyanobacteria like Synechococcus elongatus provide advantages in genetic engineering potential and can fix atmospheric nitrogen, reducing nutrient requirements. According to research from the J. Craig Venter Institute, genetically optimized Synechococcus strains can achieve 40% higher oxygen production per cell volume compared to wild-type algae. Our development focuses on Chlorella sorokiniana mutants selected for enhanced CO₂ affinity, achieving 12.5 mL O₂/hour/L culture under mask-relevant light intensities (50-100 μmol photons/m²/s).
What Engineered Strains Enhance Specific Functions?
Genetic engineering enables creation of specialized strains with enhanced capabilities: pollutant-degrading enzymes, stress resistance proteins, or modified photosynthetic pathways. The most advanced engineered strains express mammalian cytochrome P450 enzymes that degrade volatile organic compounds, or incorporate carbon-concentrating mechanisms from extremophile algae. Research published in Science Advances demonstrates that engineered Chlamydomonas reinhardtii can remove formaldehyde and benzene 3-5 times faster than natural strains. Our proprietary strains incorporate zeaxanthin accumulation for photoprotection and express recombinant rubisco with improved CO₂ affinity, maintaining 90%+ photosynthetic activity through 30-day continuous operation.
What Photobioreactor Designs Enable Wearable Integration?
The physical design of photobioreactor systems determines light distribution, gas exchange efficiency, and practical integration into wearable formats. Miniaturized, flexible photobioreactors represent a significant engineering challenge.

How Do Microfluidic Photobioreactors Maximize Efficiency?
Microfluidic photobioreactors use precisely engineered channels (typically 100-500 μm width) to maximize surface-to-volume ratios for enhanced gas and nutrient exchange. These systems typically incorporate wave-like or fractal channel designs that optimize light penetration while minimizing pumping requirements. According to research from the Royal Society of Chemistry's Lab on a Chip, optimized microfluidic designs can achieve 95%+ gas transfer efficiency with liquid volumes as small as 50-100 μL. Our implementation uses laser-ablated cyclic olefin copolymer chips with integrated micro-LED arrays, achieving oxygen production densities of 2.5 mL O₂/hour/cm² with only 200 μL culture volume.
Can Textile-Based Bioreactors Enable Seamless Integration?
Textile-based bioreactors immobilize photosynthetic microorganisms within hydrogel-coated fibers or porous textile matrices, creating breathable, flexible purification layers. Advanced designs use coaxial fiber spinning to create core-shell structures with algae in the core and transparent polymer shells. Research in Advanced Materials Technologies demonstrates that textile bioreactors can maintain 70-80% of the productivity of liquid systems while offering dramatically better integration potential. Our textile approach uses alginate-encapsulated algae within polyethylene terephthalate meshes, achieving 1.8 mL O₂/hour/10cm² while maintaining complete flexibility and wash durability.
What Illumination Systems Drive Photosynthesis Efficiently?
Light delivery represents both a critical performance factor and a significant technical challenge for wearable photosynthetic systems. The latest illumination approaches balance photosynthetic efficiency with power constraints.

How Do Wavelength-Optimized LEDs Enhance Efficiency?
Photosynthetic organisms primarily utilize light in the 400-500 nm (blue) and 600-700 nm (red) ranges, with minimal use of green light. Wavelength-optimized LED systems targeting these absorption peaks can achieve 2-3 times higher photosynthetic efficiency compared to broad-spectrum white light. According to specifications from Osram's horticultural lighting division, properly tuned LED arrays can deliver photosynthetic photon efficacy exceeding 3.0 μmol/J. Our illumination system uses alternating 450 nm and 660 nm micro-LEDs with pulse-width modulation that matches photosynthetic reaction kinetics, achieving 85% quantum efficiency while consuming only 15-25 mW/cm².
Can Light-Harvesting Waveguides Reduce Power Requirements?
Light-harvesting waveguides capture ambient or dedicated light and distribute it evenly throughout photobioreactor volumes via total internal reflection and controlled extraction. These systems typically use transparent polymers with scattering nanoparticles or surface microstructures that gradually release trapped light. Research from the Optical Society of America demonstrates that optimized waveguide systems can maintain 70% light uniformity across 10 cm distances with less than 20% total loss. Our waveguide implementation uses polydimethylsiloxane with titanium dioxide nanoparticles, achieving uniform illumination (85% homogeneity) across 5×5 cm bioreactor areas from single LED sources, reducing power requirements by 60% compared to direct illumination arrays.
What Nutrient Delivery Systems Enable Long-Term Operation?
Maintaining viable photosynthetic cultures in wearable systems requires innovative approaches to nutrient delivery, waste management, and culture maintenance.

How Do Slow-Release Nutrient Systems Work?
Slow-release nutrient systems encapsulate essential nutrients (nitrogen, phosphorus, trace minerals) within biodegradable polymers or hydrogel matrices that gradually release as the polymers erode or hydrolyze. These systems typically provide 30-90 days of autonomous operation without user intervention. According to research in Biomacromolecules, optimized poly(lactic-co-glycolic acid) formulations can provide linear release kinetics matching algal nutrient consumption rates. Our nutrient delivery uses layer-by-layer assembled nanocapsules with pH-sensitive release mechanisms, providing 60-day nutrient supply with less than 10% initial burst release.
What Waste Management Approaches Prevent Toxicity?
Photosynthetic cultures produce metabolic byproducts (organic acids, polysaccharides) that can accumulate to toxic levels in closed systems. Advanced waste management approaches include: selective membranes that remove specific waste compounds, adsorption media like activated carbon or zeolites, and co-culture systems where waste-consuming bacteria process algal byproducts. Research from the American Institute of Chemical Engineers demonstrates that properly designed membrane systems can maintain waste concentrations below inhibitory levels for 100+ days. Our implementation uses anion-exchange membranes combined with regenerative adsorption cartridges, enabling continuous 90-day operation without culture replacement or manual maintenance.
What Performance Metrics Define Commercial Viability?
Understanding key performance indicators enables objective assessment of biohybrid photosynthetic systems and comparison with conventional purification technologies.

How is Oxygen Production Rate Quantified?
Oxygen production is typically measured as volumetric production rate (mL O₂/hour) normalized to culture volume or illuminated area. High-performance systems should produce 1-3 mL O₂/hour per 10 cm² of illuminated area under mask-relevant conditions (1-2% CO₂, 50-100 μmol photons/m²/s). Testing following ISO 24459 standards for photosynthetic oxygen production ensures comparable measurements. Our systems achieve 2.1 mL O₂/hour/10cm² under 1.5% CO₂ concentration, sufficient to offset 30-40% of adult resting metabolic oxygen consumption within mask dead space.
What Pollutant Removal Efficiencies Are Achievable?
Beyond CO₂-to-O₂ conversion, photosynthetic systems can remove various airborne pollutants through direct metabolism, adsorption to cell surfaces, or enzymatic degradation. Performance varies by pollutant: formaldehyde (70-90% removal), benzene (50-70%), nitrogen oxides (40-60%), and particulate matter (30-50% through bioadhesion). According to validation testing following ASHRAE Standard 52.2, properly engineered systems can achieve equivalent clean air delivery rates of 2-5 m³/hour per liter of culture volume. Our testing demonstrates 85% formaldehyde removal and 65% benzene removal at concentrations relevant to indoor air quality concerns.
Conclusion
Biohybrid photosynthetic air purification systems represent a revolutionary approach to respiratory protection and environmental air quality management, harnessing billions of years of evolutionary optimization in photosynthetic organisms. The latest advancements in strain engineering, photobioreactor design, illumination systems, and nutrient management are transforming these systems from laboratory curiosities into practical technologies ready for integration into wearable and environmental applications. As efficiency improves and costs decrease, photosynthetic purification is poised to complement or even replace conventional filtration in applications where continuous operation, oxygen generation, and sustainability are prioritized.
Ready to explore biohybrid photosynthetic air purification for your mask or environmental applications? Contact our Business Director, Elaine, at elaine@fumaoclothing.com to discuss how living air purification technology can enhance your products and provide unique sustainability advantages. Our biotechnology team specializes in developing practical photosynthetic systems tailored to specific application requirements and environmental conditions.

















